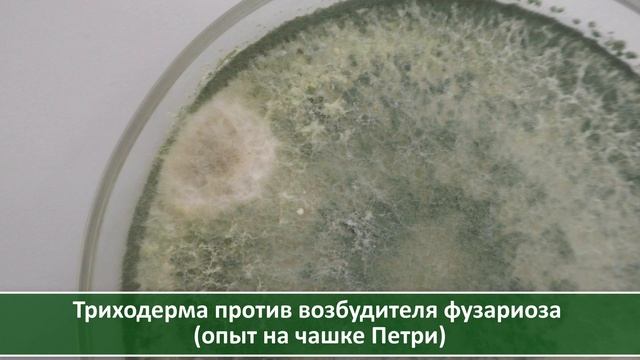
Что лучше: Максим или триходерма? Борьба с фузариозом озимого чеснока: эксперимент. Посадка осенью смотреть онлайн

Автор: Йога для создания позитивного влияния на окружающих Страница 5

Упражнения для рук Марафон здоровое тело 2020 День №5

Загадочные палатки в Лесном городке Одинцовского района

ХОЛОТРОПНОЕ ДЫХАНИЕ. Сколько дышать?

ИСЦЕЛЯЮЩАЯ СИЛА МАТЕРИ. АВТОР ИМРАМ КРИЙЯ. ЯСНОВИДЕЦ

ПРОМО РОЛИК Анимационной компании «Komanda StasyaDance»

7-класс | История | Государство Моголистан.Кыргызы Тянь-Шаня и Восточного Туркестана

Йога ? низкое давление

Шьем детские спортивные штаны из футера

Лекция «Философия Древнего Востока»

Маленькая мисс «Академический» 2016. №31 – Крылова Арина

Признаки человека нового времени

Best Lenovo Yoga Laptop in India 2022 ⚡ BEST LENOVO YOGA SERIES LAPTOPS ⚡ लेनोवो योगा लैपटॉप ⚡

Lenovo Yoga 2 11.6" Review

Funny Stacy doing shopping with cute Dog Toy
Что лучше: Максим или триходерма? Борьба с фузариозом озимого чеснока: эксперимент. Посадка осенью

Пермь-Закамск

QUEEN EN WEMBLEY 1986 UNDER PRESSURE

Отзыв ТТС 2018 Зыкова Надежда

Танцевальная Йога смеха

Иркутск,08.02.22

ЙОГА для БЕРЕМЕННЫХ урок 1 с Фирсовой Екатериной на таймстади ру!

4 занятие 8 часть. Иркутск, 23-25 февраля 2007 г.

ДЕЛАЕМ БОЛЬШУЮ НАДПИСЬ

Будьте здоровы ))))
За каждым успешным каналом стоит личность, идея и сотни часов кропотливого труда. Если вы здесь, значит, автор «Йога для создания позитивного влияния на окружающих» уже сумел зацепить ваше внимание своим уникальным стилем или подачей. А мы на RUVIDEO позаботились о том, чтобы вы могли изучить весь архив его работ в максимально комфортных условиях — без лишней суеты и преград.
Почему за работами канала «Йога для создания позитивного влияния на окружающих» так интересно наблюдать? Всё просто: это честный контент, который находит отклик в сердцах зрителей. На нашем ресурсе вы можете смотреть онлайн все видео любимого автора бесплатно и в хорошем качестве. Нам важно, чтобы вы видели каждую деталь и слышали каждый нюанс, поэтому мы используем только стабильные плееры из открытых источников Rutube.
Следите за новинками канала, пересматривайте старые шедевры и открывайте для себя новые грани творчества «Йога для создания позитивного влияния на окружающих». Мы постоянно обновляем ленту, чтобы у вас под рукой всегда были самые свежие выпуски. Никаких сложных регистраций — только вы и творчество, которое вдохновляет. Приятного вам путешествия по миру авторского контента на RUVIDEO!
Видео взято из открытых источников Rutube. Если вы правообладатель, обратитесь к первоисточнику.